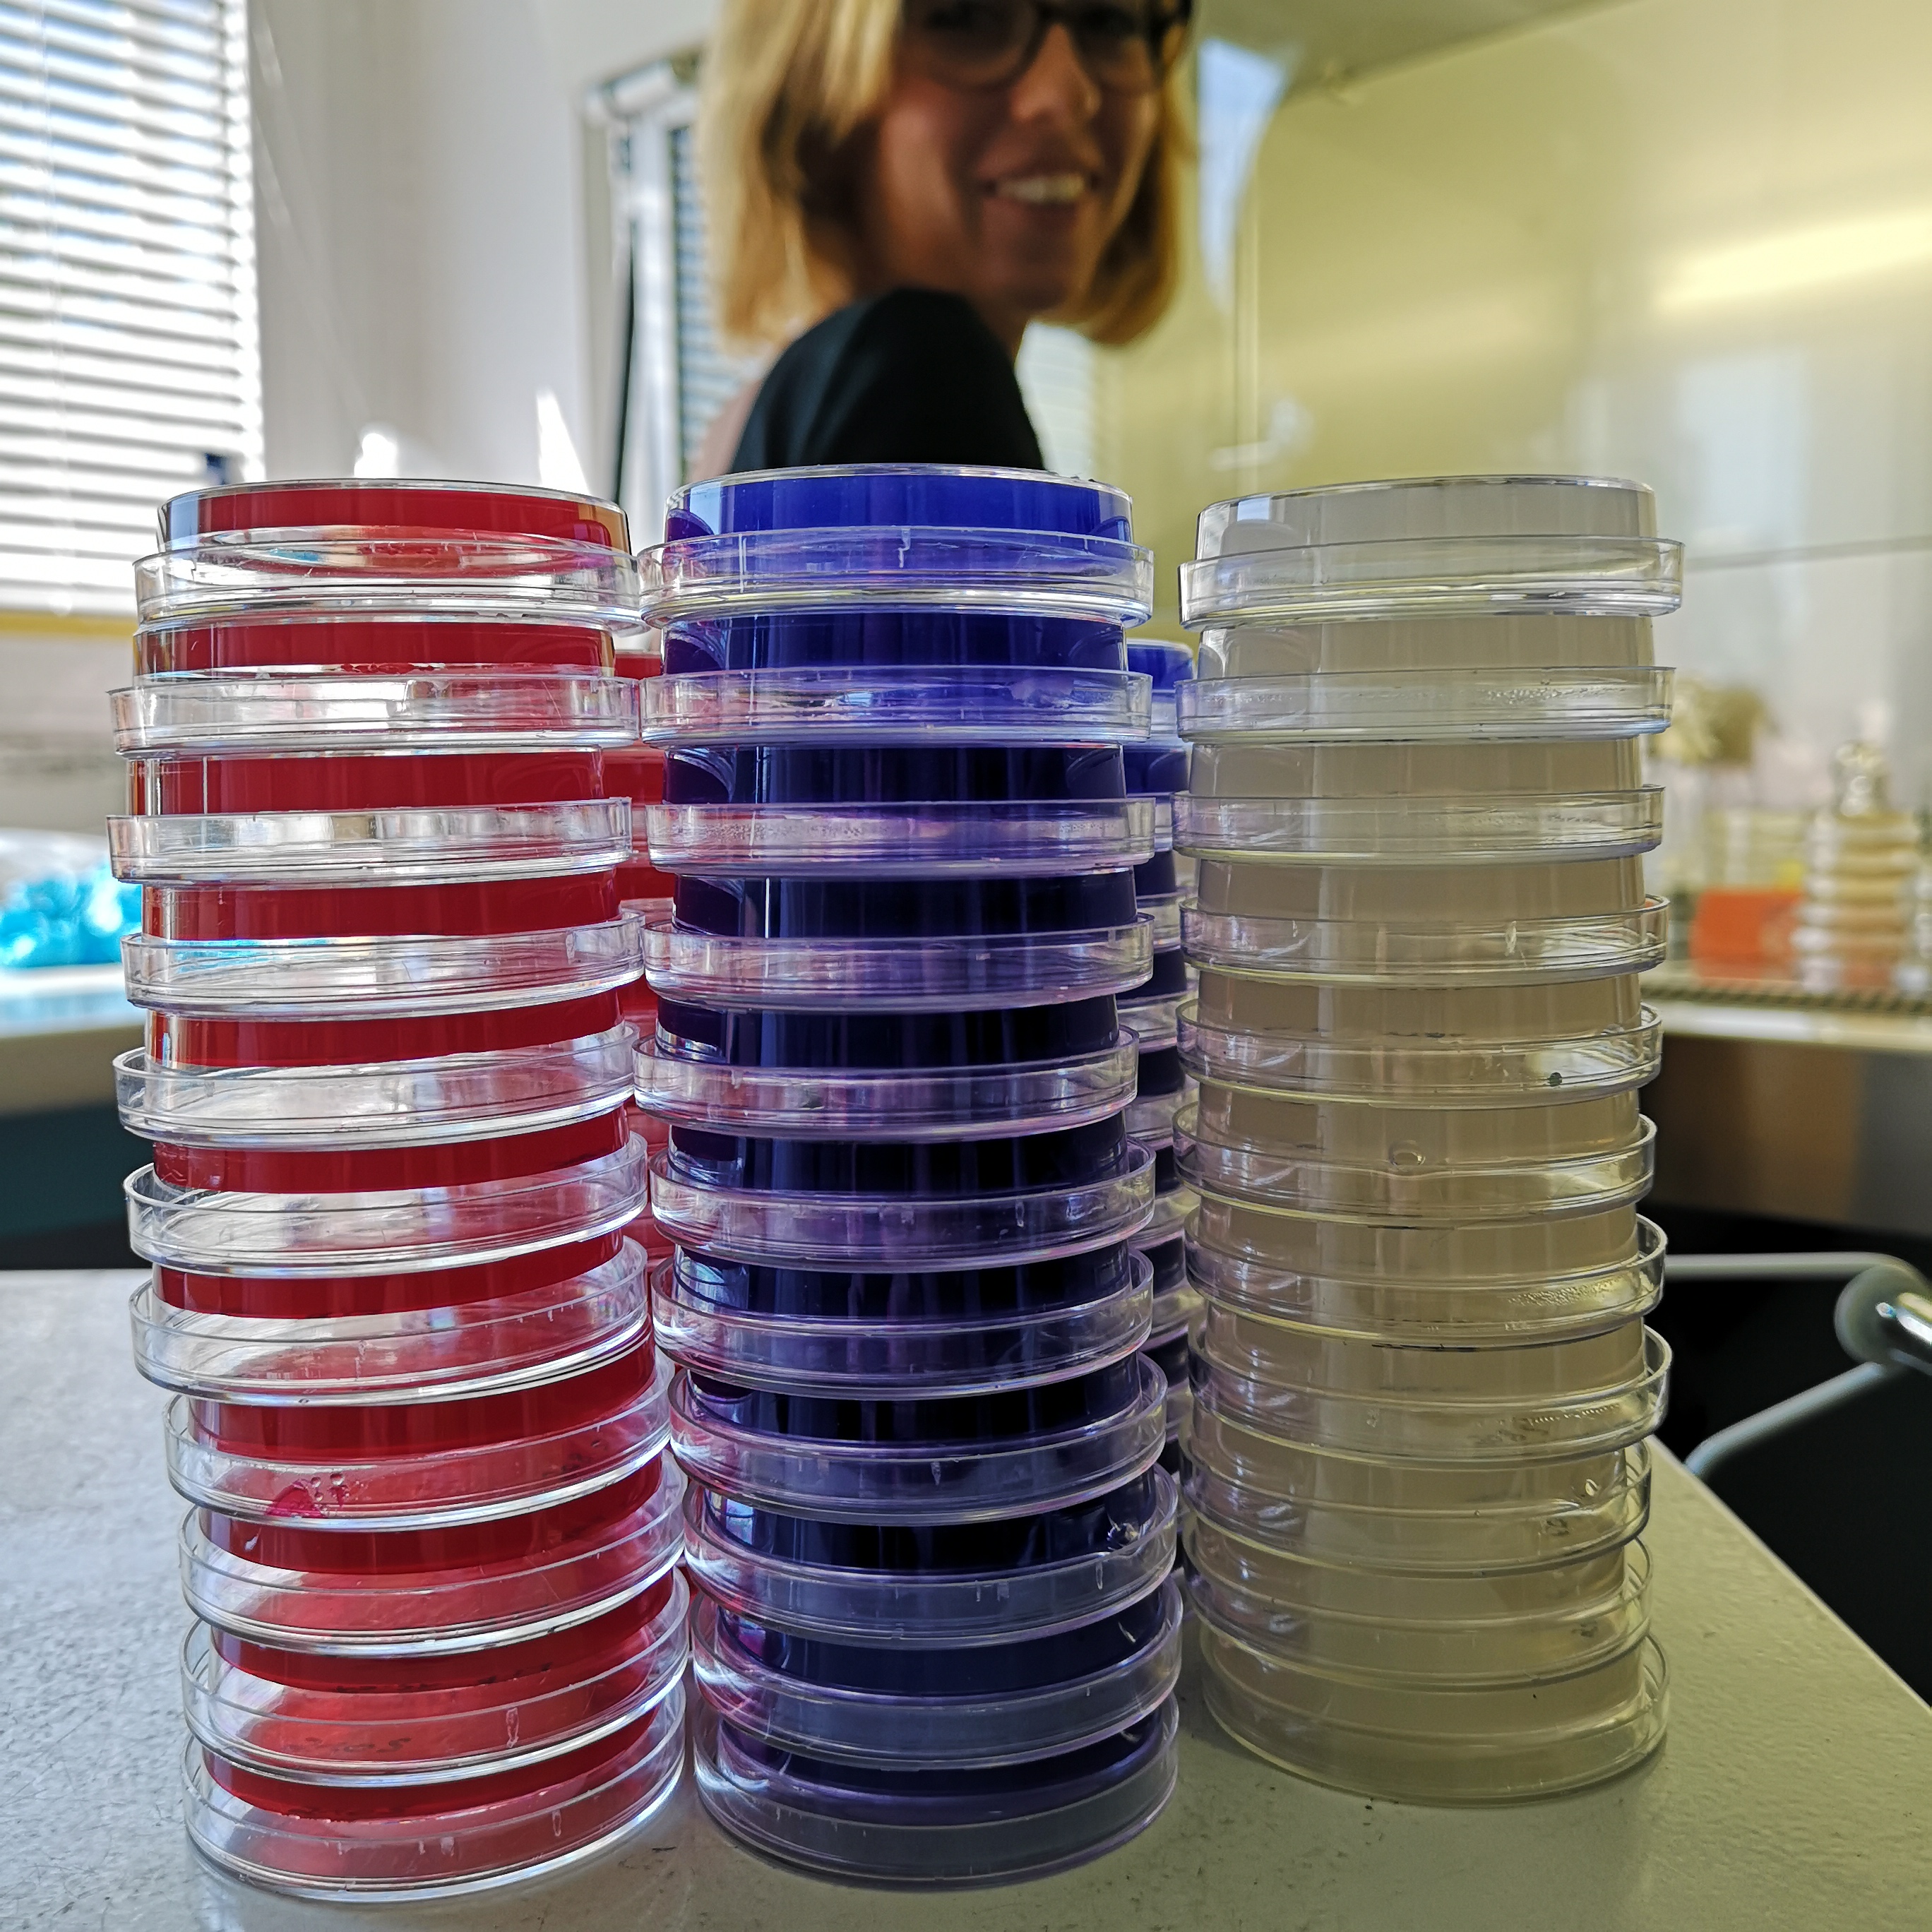
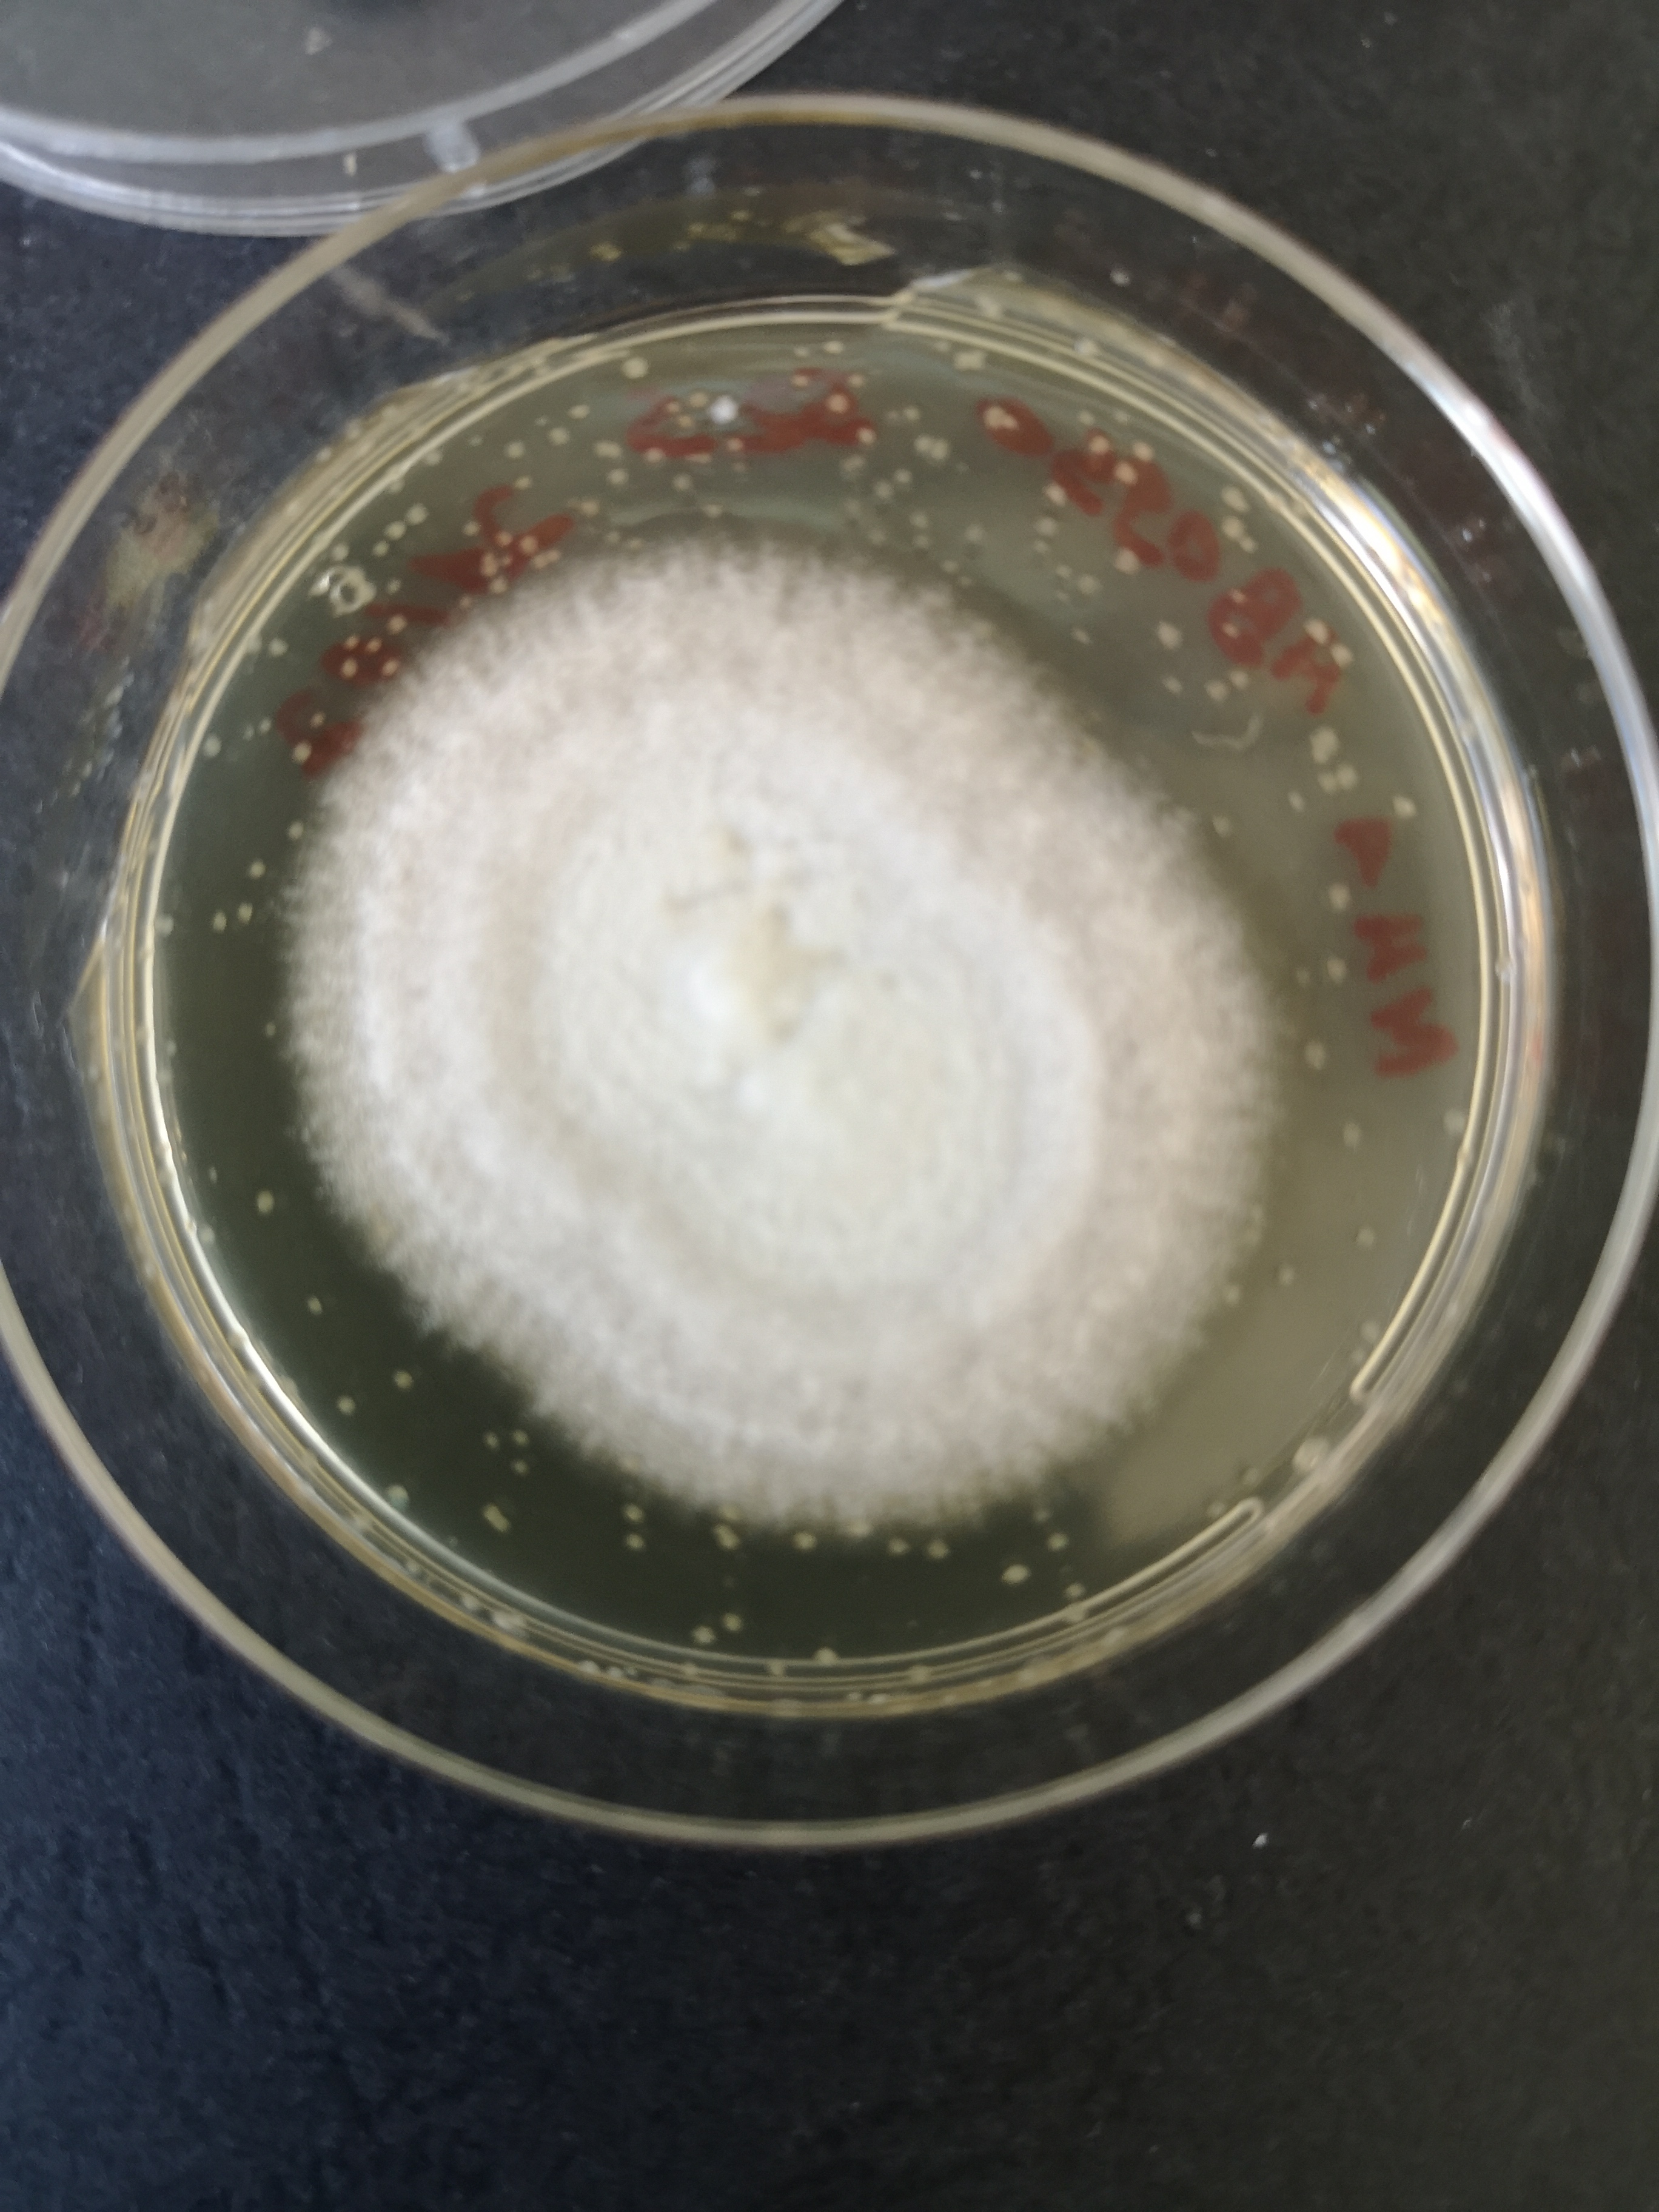
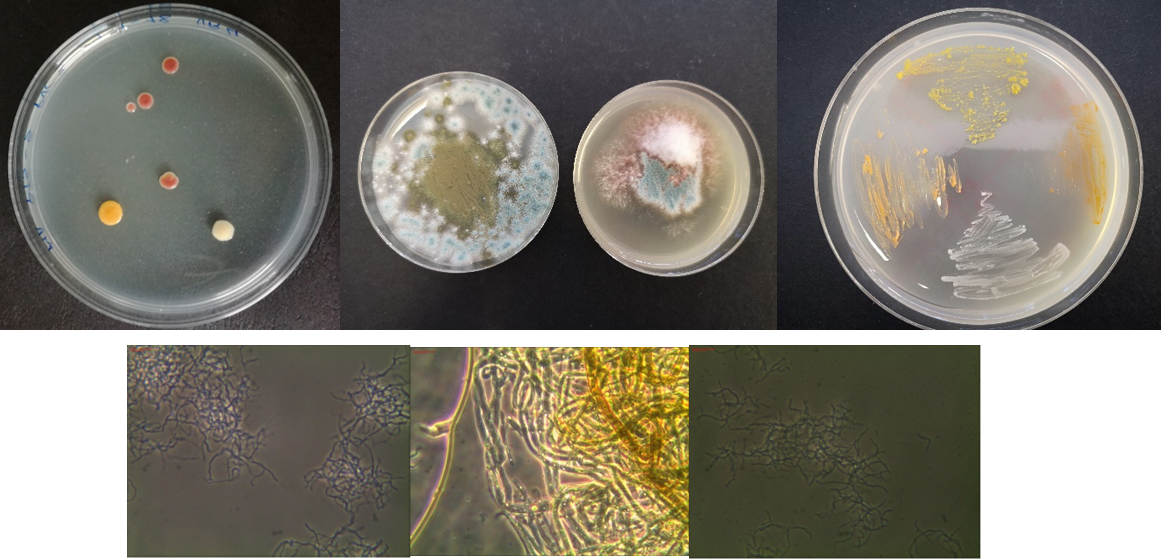
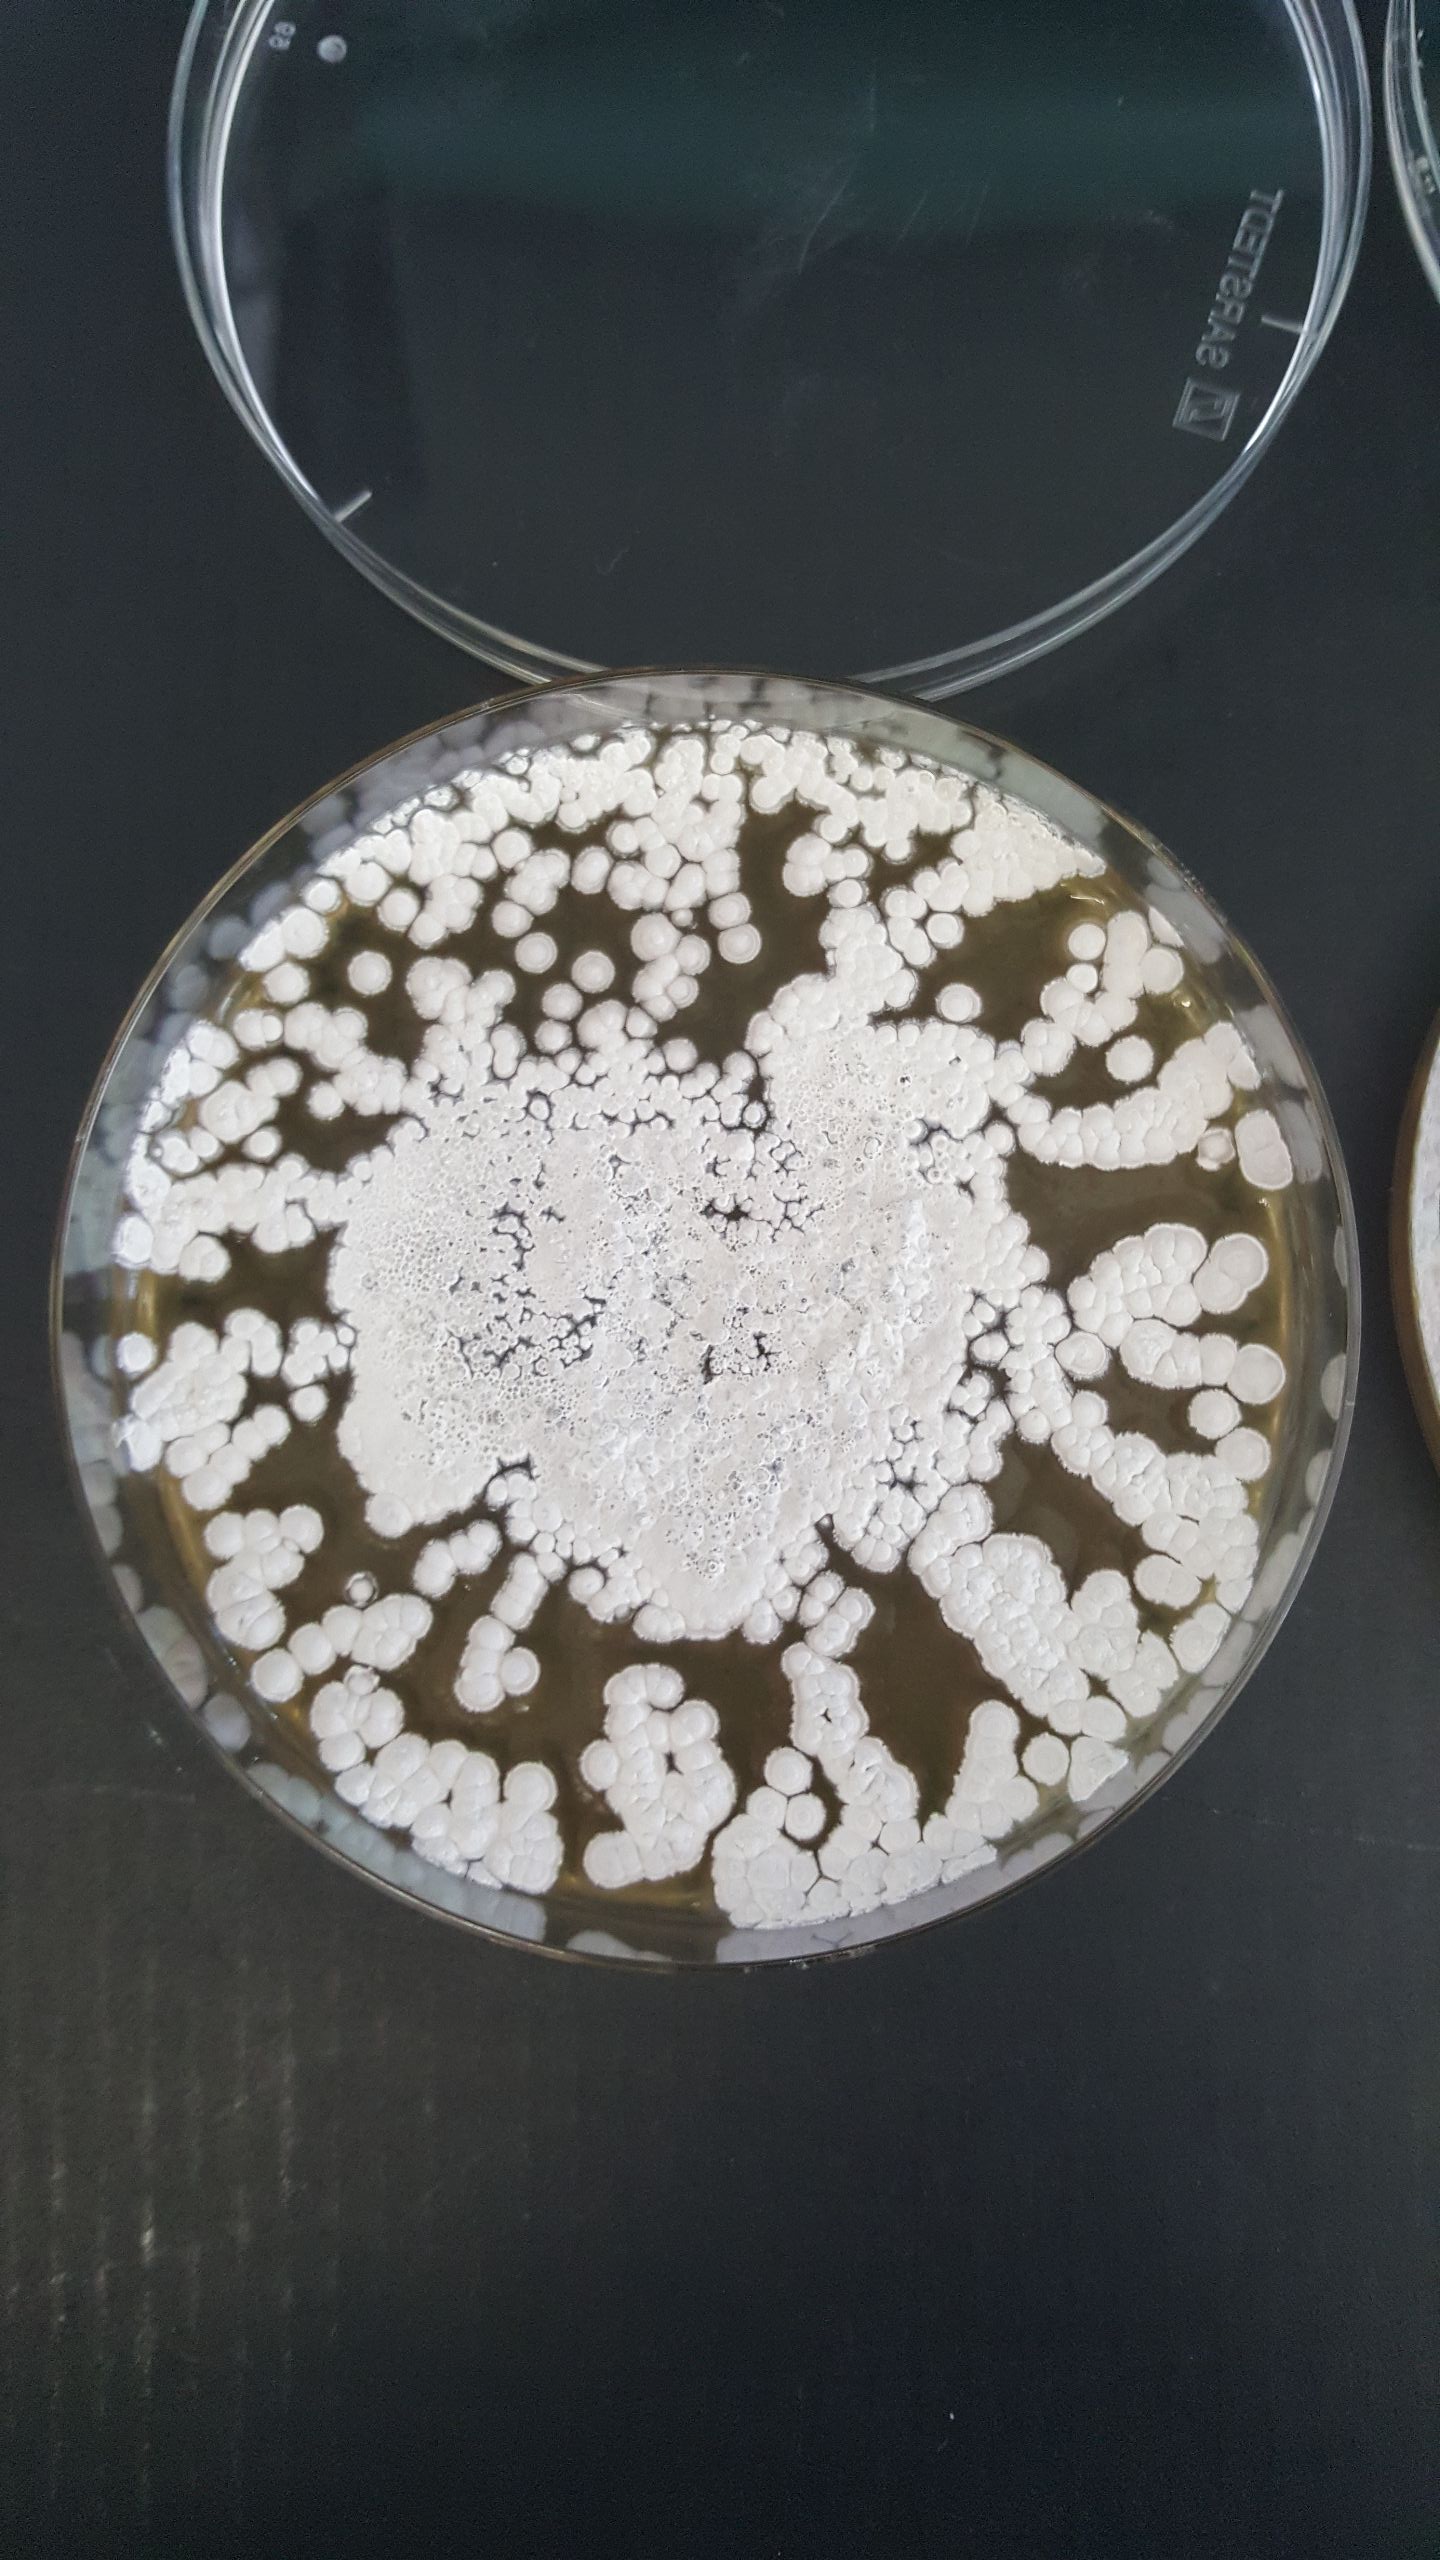
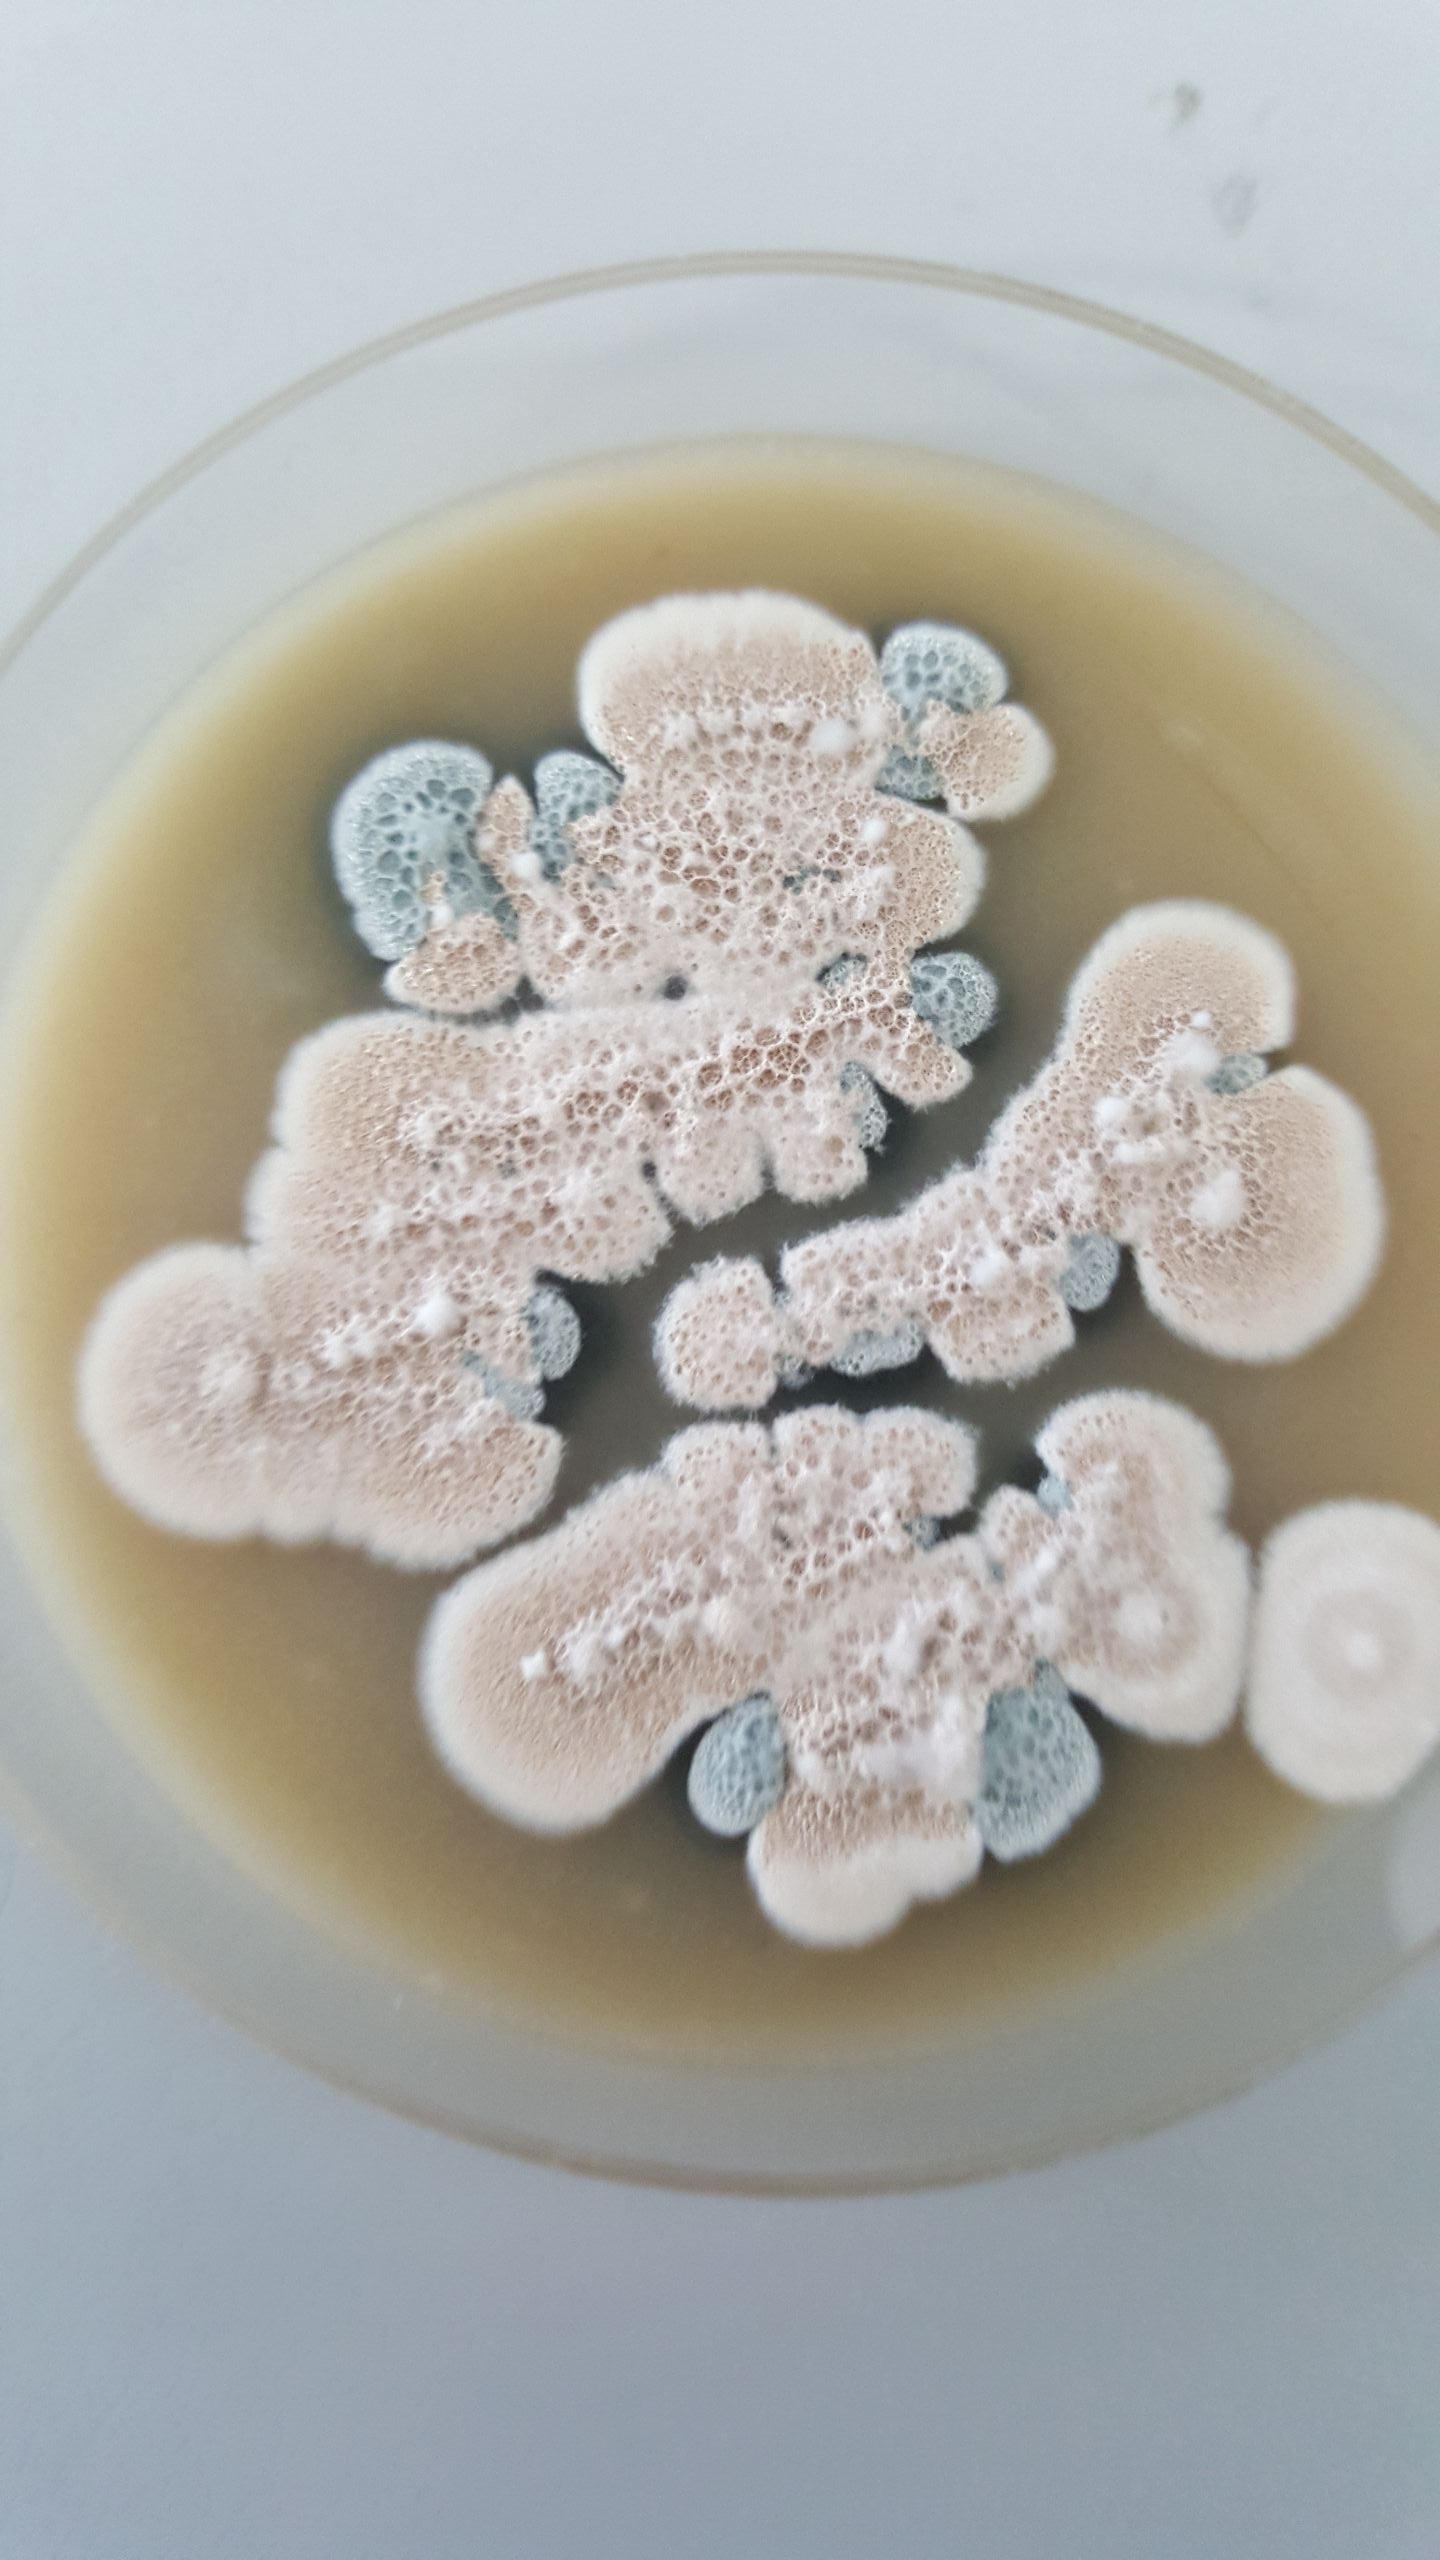
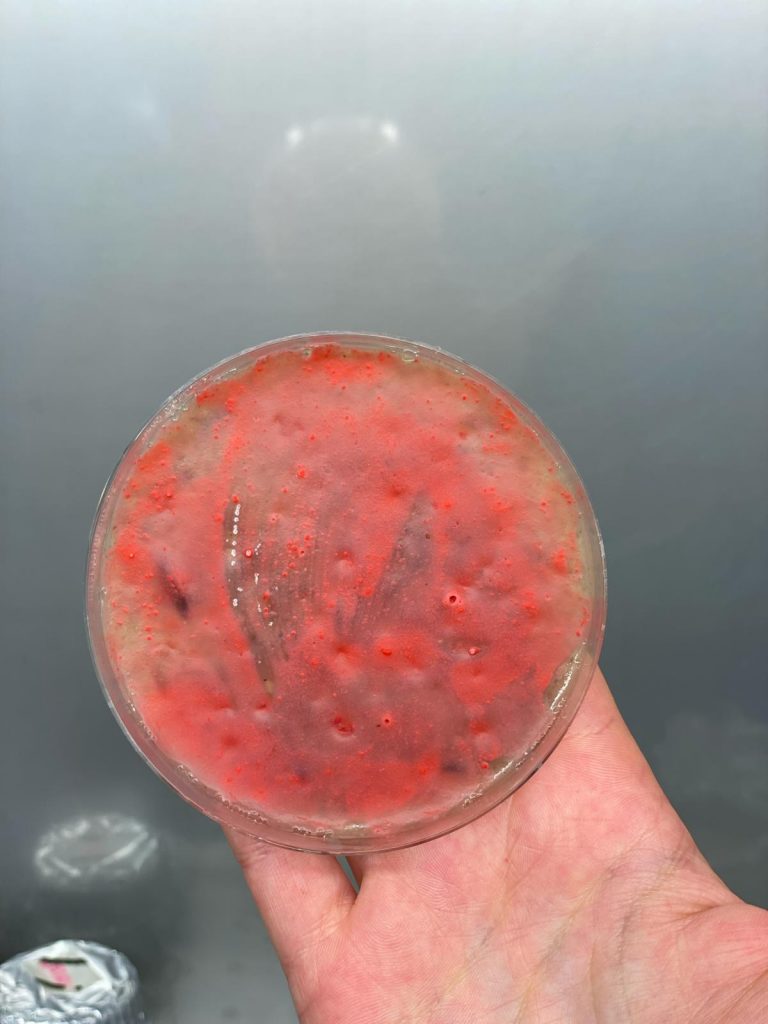

Prof. Corina-Diana Ceapă from the National Autonomous University of Mexico, held a Bioinformatic Course titled “Natural Product Discovery: bioinformatic analyses for beginners” open to PhD students and researchers intereseted.
She also held a seminar titled “Integrating Genomic Exploration and Molecular Epidemiology: New Frontiers in Antibiotic Discovery and Multidrug-Resistant Pathogen Control in Mexico”


Lorenzo, Francesca and Elisa, attended the International Micorbiological Societies Congress (IUMS2024) held in Florence, Palazzo di Congressi (23-25th October)
Prof. Flavia Marinelli was part of the Organization Commitee as BAM Specialist




Melissa wins the Franco Tatò Award for the best PhD Thesis in Microbial Biotechnology (Cortona, June 2024)
Our Post-doc Melissa and our PhD students Letizia, Lorenzo and Davide attending 48th FEBS Congress in Milan
Dr. Andrew Truman from John Innes Centre of Norwich held a lecture for the Master Students of Pharmaceutical Biotechnology about secondary metabolites and antibiotics


Prof. Flavia Marinelli held a Lectio Magistralis 𝗪𝗵𝗲𝗿𝗲 𝗱𝗼 𝗮𝗻𝘁𝗶𝗯𝗶𝗼𝘁𝗶𝗰𝘀 𝗰𝗼𝗺𝗲 𝗳𝗿𝗼𝗺 𝗻𝗮𝘁𝘂𝗿𝗲? 𝗟𝗲𝘀𝘀𝗼𝗻𝘀 𝗳𝗿𝗼𝗺 𝘁𝗵𝗲 𝗥&𝗗 𝗼𝗳 𝗼𝗹𝗱 𝗮𝗻𝗱 𝗻𝗲𝘄 𝗴𝗹𝘆𝗰𝗼𝗽𝗲𝗽𝘁𝗶𝗱𝗲 𝗮𝗻𝘁𝗶𝗯𝗶𝗼𝘁𝗶𝗰𝘀, during the meeting “Ricerca e sviluppo nella filiera farmaceutica”, organized by University of Salento.













Lab’s dinner

Lab life and much more…
Notte dei ricercatori 2022
Notte dei ricercatori 2022

Notte dei ricercatori 2022




Some microbiology…..